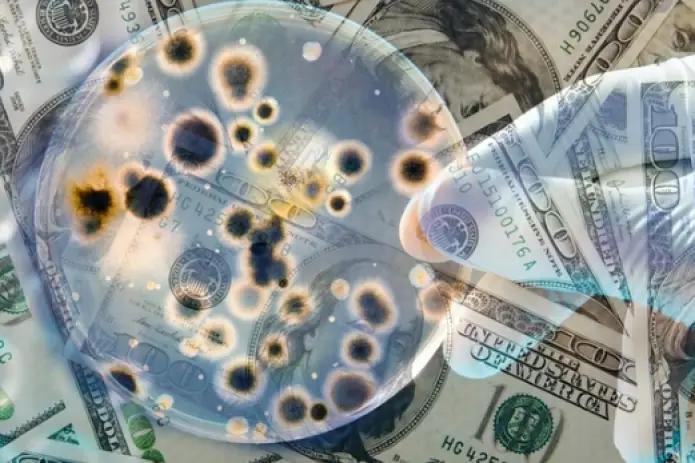
ВОЗ: Коронавирус не передается через банкноты

Опубликовано
09.04.2020, 08:17Всемирная организация здравоохранения (ВОЗ) опровергла появившиеся в СМИ сообщения об опасности наличных денег в связи с распространением коронавируса COVID-19. Научных доказательств повышенного риска заражения новым вирусом через банкноты нет.
[news 23014]
«ВОЗ никогда не заявляла, что наличные могут переносить COVID-19. Мы не делали официальных заявлений по этому поводу», — сказала пресс-секретарь ВОЗ Фадела Чейб на международном финансовом портале Market Watch.
ВОЗ в свою очередь напоминает о необходимости соблюдать надлежащую гигиену рук, в том числе после контакта с наличными деньгами. К купюрам стоит относиться так же, как и к другим вещам, которые могли трогать инфицированные, — к дверным ручкам, документам и так далее.
Европейская ассоциация перевозчиков ценностей (ESTA), объединяющая 127 мировых компаний, специализирующихся на управлении наличным оборотом, и Европейский центральный банк исключают распространение коронавируса через банкноты. В докладе говорится, что Eurosystem регулярно проводит исследования потенциального воздействия банкнот евро на здоровье населения.
Как отмечается, чтобы купюра представляла угрозу заражения, «нужно использовать ее не по назначению, например прикрываться при чихании».
«На самом деле, деньги — неблагоприятная среда для выживания вирусов», — говорит доктор Кристин Тет-Бюркар, эксперт по инфекциям и иммунитету в Институте Рослина Эдинбургского университета.
Некую опасность в связи с распространением коронавируса могут представлять банкоматы, услугами которых за день пользуются сотни людей. Они касаются экранов, вводят PIN-код на клавиатуре. Однако представители компаний, оказывающих услуги по обслуживанию банковского оборудования, утверждают, что кредитные организации в целях сокращения рисков заражения используют эффективные средства для дезинфекции банкоматов.
«Мы подготовили рекомендации для банков по обслуживанию банкоматов в период карантина. Наши специалисты, которые осуществляют техническую поддержку устройств самообслуживания, оснащены всеми необходимыми средствами индивидуальной защиты. Они дополнительно обрабатывают специальными дезинфицирующими средствами все поверхности терминалов, что минимизирует риск заражения вирусом COVID-19 через банкоматы», — говорит Томас Аугуцявичюс, заместитель генерального директора компании BS/2, которая предоставляет банковские решения и сервисные услуги в 13 странах.



